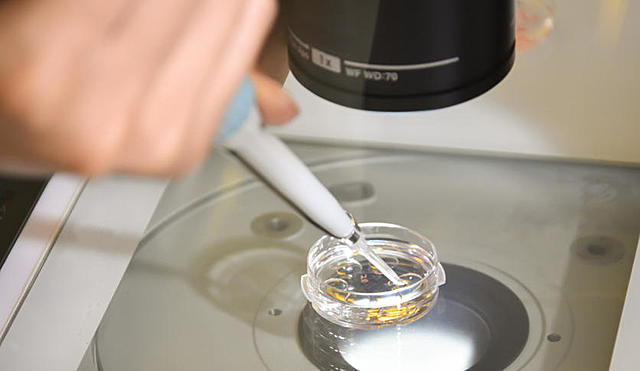
Estado unidos

-
Es un proceso por el que se consigue de forma asexual, copias idénticas de un organismo célula o molécula.
-
Empezó en el instituto de Roslin, la célula proviene de una oveja adulta
-
El Consejo de Europa adopta un protocolo que prohíbe la clonación humana
-
Investigadores de la Universidad de Hawaii (EEUUE) aseguran haber clonado tres generaciones de ratones a partir de células adultas.
-
El gobierno japonés aprueba una ley que impone multas y penas de prisión para las personas que participen en proyectos de clonación humana.
-
EEUU aprueba una ley similar a la japonesa para los investigadores que creen embriones humanos o personas para investigar.
-
La Cámara de los Lores británica autoriza la clonación de embriones con fines terapéuticos y la creación del primer banco de células embrionarias.
Want to make a timeline like this?
Use Timetoast to turn dates, events, milestones, and phases into a clear visual timeline you can build and share. Timetoast is a timeline maker for work, school, research, and stories.